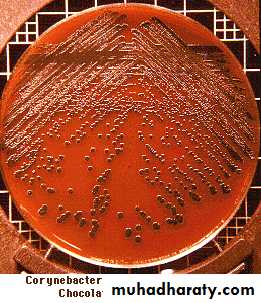
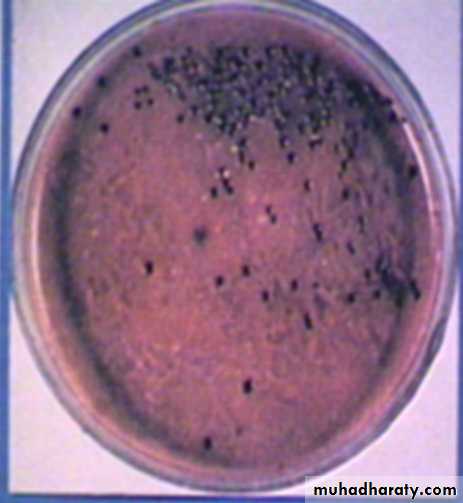

3rd stage
Oral Mirobiology / Dr. Zubaida NajatLactobacilus
Propionibacteria
CorynebacteriumLactobacilli
are saprophytes in vegetable and animal material (e.g. milk).Some species are common animal and human commensals inhabiting the oral cavity and other parts of the body.
They have the ability to tolerate acidic environments and hence are believed to be associated with the carious process.
• The taxonomy of lactobacilli is complex. They are characterized into two main groups: homofermenters, whichproduce mainly lactic acid (65%) from glucose fermentation (e.g. Lactobacillus casei),
• and heterofermenters, which produce
• lactic acid as well as acetate, ethanol and carbon dioxide (e.g. Lactobacillus fermentum).
• L. casei and Lactobacillus rhamnosus, Lactobacillus acidophilus and the newly described species, Lactobacillus oris, are common in the oral cavity.
Habitat and transmission
Lactobacilli are found in the oral cavity, gastrointestinal tract and female genital tract.In the oral cavity, they constitute less than 1% of the total flora.
Transmission routes are unknown
Lactobacilli are also major constituents of the vaginal flora and help maintain its low pH equilibrium.
Recently, the benefcial role of lactobacilli in maintaining the homoeostasis of the intestinal flora has been recognized, and ‘lactobacillus-laced’ food items have gained popularity among the health-conscious public.
Culture and identifcation
Lactobacilli grow under microaerophilic conditions in the presence of carbon dioxide and at acidic pH (6.0).Media enriched with glucose or blood promote growth. A special selective medium,
tomato juice agar (pH 5.0), promotes the growth of lactobacilli while suppressing other bacteria.Identifcation is by biochemical reactions.
Characteristics
Gram-positive coccobacillary forms (mostly bacillary),
α- or non-haemolytic, facultative anaerobes.
These organisms ferment carbohydrates to form acids (i.e. they are acidogenic) and can survive well in acidic milieu (they are aciduric); they may be
homofermentative or heterofermentative.
The question as to whether they are present in carious lesions because they prefer the acidic environment, or whether they generate an acidic milieu and destroy the tooth enamel, has been debated for years (the classic ‘chicken and egg’ argument).
Dr.T.V.Rao MD
8• Pathogenicity
Lactobacilli are frequently isolated from deep carious lesions where the pH tends to be acidic.Indeed, early workers believed that lactobacilli were the main cariogenic agent (atheory that has been disproved), so much so that the number of lactobacilli in saliva (the lactobacillus count) was taken as an indication of an individual’s caries activity.
Although this test is not very reliable, it is useful for monitoring the dietary profile of a patient because the level of lactobacilli correlates well with the intake of dietary carbohydrates
Definition
• Diphtheria is an acute, toxin-mediated disease caused by toxigenic Corynebacterium diphtheriae• It’s a very contagious and potentially life-threatening bacterial disease.
• It’s a localized infectious disease, which usually attacks the throat and nose mucous membrane
Corynebacteria
The genus Corynebacterium contains many species that arewidely distributed in nature.
These Gram-positive bacilli demonstrate pleomorphism (i.e. coccobacillary appearance) and are non-sporing, non-capsulate and non-motile.
The sometimes fatal upper respiratory tract infection of childhood diphtheria is caused by Corynebacterium diphtheriae. It is important to distinguish this, and other pathogens within the genus, from commensal corynebacteria.
Corynebacterium diphtheriae
Habitat and transmissionHuman throat and nose, occasionally skin; patients carry toxigenic organisms up to 3 months after infection.Transmission
• Transmission is most often person-to-person spread from the respiratory tract
• (by small droplet when coughing or sneezing).
• Rarely, transmission may occur from skin lesions or articles soiled with discharges from lesions of infected persons
Characteristics
Pleomorphic, Gram-positive, club-shaped (tapered at one end) bacilli, 2–5 µm in length, arranged in palisades.They divide by ‘snapping fission’ and hence are arranged at angles to each other, resembling Chinese characters. The rods have a beaded appearance, with the beads comprising an intracellular store of polymerized phosphate.
The granules stain metachromatically with special stains such as Neisser methylene blue stain (i.e. the cells are stained with blue and the granules in red).
14
Culture and identifcation
A non-fastidious, facultative anaerobe that grows well at 37°C.Grows on blood agar but selective media are helpful for isolation from clinical specimens.
In blood tellurite agar, commonly used for this purpose, corynebacteria produce distinctive grey-black colonies after 48-h incubation at 35°C.Preliminary identifcation is helped by the shape and size of the colonies on tellurite agar.
Specific identification is by biochemical reactions and demonstration of toxin production.
The test for toxin production is important as some corynebacteria are non-toxigenic (and hence non-virulent) and are normal skin or throat commensalsCommonly used medium
Tellurite blood agar Contains tellurite 0.04 tellurite Inhibits other bacteriaProduce Grey/Black colonies.
Gram +ve Bacilli and Colonies
Toxin production
The exotoxin responsible for virulence can be demonstrated by the gel precipitation test, which uses the Elek plate in Vitro& Animale inoculation in Vivo
In Vitro Elek testIn this test, a flter paper soaked in diphtheria antitoxin is incorporated into serum agar before it has set; the test strain of C. diphtheriae under investigation is then streaked on to the agar at right angles to the filter-paper strip and incubated at 37°C. After 24 h, white lines of precipitation will be visible as a result of the combination of the antitoxin and the antigen (i.e. the toxin) if the strain is a toxigenic isolate .
• Although this is the traditional method for toxin detection,
• - Enzyme-linked immunosorbent assays (ELISAs) and immunochromographic strips are now available for quick detection of the exotoxin from the cultured isolates.- A rapid diagnostic test based on polymerase chain reactionfor the toxin gene (tox) is another new direct assay of patientspecimens.Diphtheria toxin
• This exotoxin – produced by strains carrying bacteriophages with the tox gene – inhibits protein biosynthesis in all eukaryotic cells.• The toxin has two components:
• Subunit A, Active site
Enzyme
Blocks protein synthesis
ADP-ribosyl transferase
elongation factor 2 (EF2)
• .
Diphtheria Toxin: Part B
Binding SiteBinds to cell receptor
Bound receptor internalized
Endosome
Hydrolyzed by protease
Disulfide broken
Part A released
Macroscopically, its action on the respiratory mucosa results in the production of a grey, adherent pseudomembrane comprising bacteria, fbrin and epithelial and phagocytic cells.
This may obstruct the airway, and the patient may die of asphyxiation.
When the toxin permeates into the blood stream, it acts systemically, affecting motor nerves of the myocardium and the nervous system.The toxin can be converted to a toxoid (i.e. made nontoxic but still antigenic) by treatment with formaldehyde; thetoxoid can then be used for prophylactic immunization – thefirst component of the diphtheria–tetanus–pertussis (DTP)vaccine
Antitoxin, produced by injecting the toxin into horses, neutralizes the toxin
Dr.T.V.Rao MD
24Pathogenicity
C. diphtheriae is the agent of diphtheria; it usually affects the mucosa of the upper respiratory(nasopharynx tract, or anteror narse) skin, miidle ear.Cutaneous infections are especially seen in the tropics and are usually mixed infections with Staphylococcus aureus and/or Streptococcus pyogenes.
Serious systemic manifestations are the result of the absorption of the exotoxin.
Dr.T.V.Rao MD
26Treatment and prevention
In the acute phase, supportive therapy to maintain the airway is critical.Antitoxin is given to neutralize the toxin and penicillin to kill the organisms.
In epidemic outbreaks, carriers are given either penicillin or erythromycin.Immunization is highly effective in preventing diphtheria.A special test (the Schick test) is used to demonstrateimmunity. Here, the circulating level of antibody after immunization (or clinical/subclinical infection) is assessed by inoculating a standardized dose of the toxin.
Schick Test
Injection of toxin IDProduces redness/erythematic in 2-4 days
No reaction – Protective immunity present.
Other corynebacteria
Corynebacterium ulcerans is responsible for diphtheria-like throat lesions, but it does not cause toxaemia.Corynebacterium (formerly Bacterionema) matruchotti is the only true coryneform organism in the oral cavity.
Diphtheroids
Bacilli that morphologically resemble diphtheria bacilli are called diphtheroids
(e.g. Corynebacterium hofmannii, Corynebacterium xerosis).
They are normal inhabitants of the skin and conjunctiva and are occasional opportunistic pathogens in compromised patients
(e.g. endocarditis in prosthetic valves).
Propionibacteria
Propionibacteria are obligate anaerobic, Gram-positive rods, sometimes called ‘diphtheroids’Propionibacterium acnes is part of the normal skin flora and may also be isolated from dental plaque.
• Acne is follicle-associated lesions
The pathogenesis of facial acne is closely related to the lipases produced by P. acnes, hence the name.A new member of this genus is Propionibacterium propionic morphologically similar toActinomyces israelii (except for the production of propionic acid from glucose by the former)